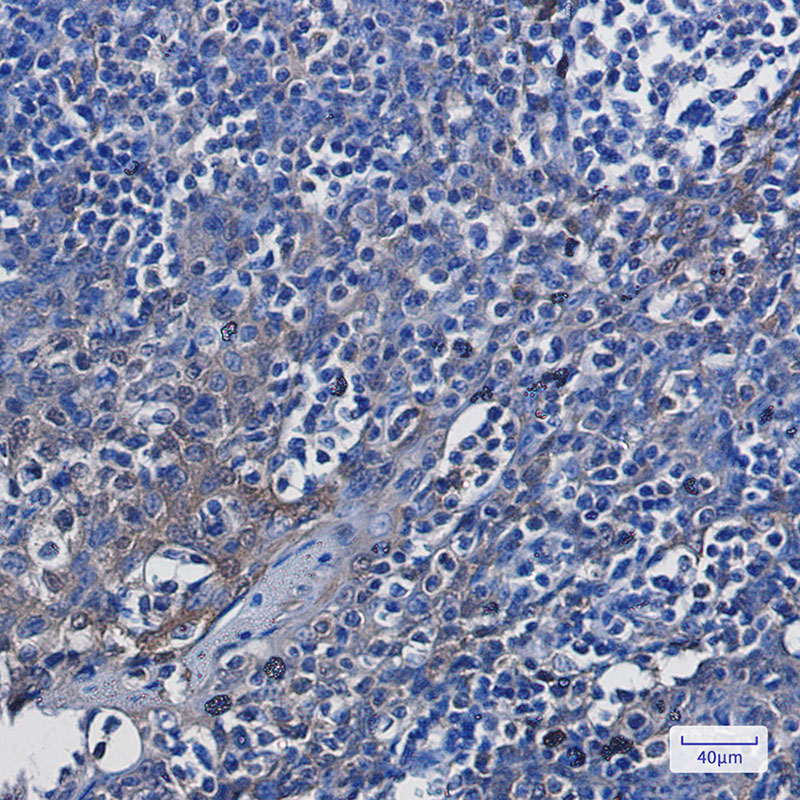
4 - ENO1 Rabbit mAb AP75001

ENO1 Rabbit mAb
- 产品详情
- 实验流程
- 背景知识
Application
| WB, IHC-P, IHC-F, FC, IP |
|---|---|
| Primary Accession | P06733 |
| Reactivity | Rat, Human, Mouse |
| Host | Rabbit |
| Clonality | Monoclonal Antibody |
| Isotype | IgG |
| Conjugate | Unconjugated |
| Purification | Affinity Purified |
| Calculated MW | 47169 Da |
| Gene ID | 2023 |
|---|---|
| Other Names | ENO1 |
| Dilution | WB~~1:500-1:1000 IHC-P~~1:50~200 IHC-F~~N/A FC~~1:200-1:500 IP~~1:20-1:50 |
| Format | Liquid in 50mM Tris-Glycine(pH 7.4), 0.15M NaCl, 40%Glycerol, 0.01% sodium azide and 0.05% BSA. |
| Storage | Store at 4°C short term. Aliquot and store at -20°C long term. Avoid freeze/thaw cycles. |
| Name | ENO1 (HGNC:3350) |
|---|---|
| Synonyms | ENO1L1, MBPB1, MPB1 |
| Function | Enolase that catalyzes the conversion of 2-phosphoglycerate to phosphoenolpyruvate in glycolysis and the reverse reaction in gluconeogenesis (PubMed:1369209, PubMed:29775581). Also involved in various processes such as growth control, hypoxia tolerance and allergic responses (PubMed:10802057, PubMed:12666133, PubMed:2005901, PubMed:29775581). May also function in the intravascular and pericellular fibrinolytic system due to its ability to serve as a receptor and activator of plasminogen on the cell surface of several cell-types such as leukocytes and neurons (PubMed:12666133). Stimulates immunoglobulin production (PubMed:1369209). |
| Cellular Location | Cytoplasm. Cell membrane. Cytoplasm, myofibril, sarcomere, M line. Note=Can translocate to the plasma membrane in either the homodimeric (alpha/alpha) or heterodimeric (alpha/gamma) form. ENO1 is localized to the M line |
| Tissue Location | The alpha/alpha homodimer is expressed in embryo and in most adult tissues. The alpha/beta heterodimer and the beta/beta homodimer are found in striated muscle, and the alpha/gamma heterodimer and the gamma/gamma homodimer in neurons |
For Research Use Only. Not For Use In Diagnostic Procedures.
Provided below are standard protocols that you may find useful for product applications.
BACKGROUND
Multifunctional enzyme that, as well as its role in glycolysis, plays a part in various processes such as growth control, hypoxia tolerance and allergic responses. May also function in the intravascular and pericellular fibrinolytic system due to its ability to serve as a receptor and activator of plasminogen on the cell surface of several cell-types such as leukocytes and neurons. Stimulates immunoglobulin production.MBP1 binds to the myc promoter and acts as a transcriptional repressor. May be a tumor suppressor.MiscellaneousUsed as a diagnostic marker for many tumors and, in the heterodimeric form, alpha/gamma, as a marker for hypoxic brain injury after cardiac arrest. Also marker for endometriosis. Antibodies against alpha-enolase are present in sera from patients with cancer-associated retinopathy syndrome (CAR), a progressive blinding disease which occurs in the presence of systemic tumor growth, primarily small-cell carcinoma of the lung and other malignancies. Is identified as an autoantigen in Hashimoto encephalopathy (HE) a rare autoimmune disease associated with Hashimoto thyroiditis (HT). HT is a disorder in which destructive processes overcome the potential capacity of thyroid replacement leading to hypothyroidism.
终于等到您。ABCEPTA(百远生物)抗体产品。
点击下方“我要评价 ”按钮提交您的反馈信息,您的反馈和评价是我们最宝贵的财富之一,
我们将在1-3个工作日内处理您的反馈信息。
如有疑问,联系:0512-88856768 tech-china@abcepta.com.























 癌症的基本特征包括细胞增殖、血管生成、迁移、凋亡逃避机制和细胞永生等。找到癌症发生过程中这些通路的关键标记物和对应的抗体用于检测至关重要。
癌症的基本特征包括细胞增殖、血管生成、迁移、凋亡逃避机制和细胞永生等。找到癌症发生过程中这些通路的关键标记物和对应的抗体用于检测至关重要。 为您推荐一个泛素化位点预测神器——泛素化分析工具,可以为您的蛋白的泛素化位点作出预测和评分。
为您推荐一个泛素化位点预测神器——泛素化分析工具,可以为您的蛋白的泛素化位点作出预测和评分。 细胞自噬受体图形绘图工具为你的蛋白的细胞受体结合位点作出预测和评分,识别结合到自噬通路中的蛋白是非常重要的,便于让我们理解自噬在正常生理、病理过程中的作用,如发育、细胞分化、神经退化性疾病、压力条件下、感染和癌症。
细胞自噬受体图形绘图工具为你的蛋白的细胞受体结合位点作出预测和评分,识别结合到自噬通路中的蛋白是非常重要的,便于让我们理解自噬在正常生理、病理过程中的作用,如发育、细胞分化、神经退化性疾病、压力条件下、感染和癌症。